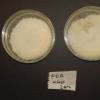
message #49059

09-04-2026 15:25
Jac GelderblomOn bare soil between mosses Ifound an asco I deter

09-04-2026 13:55
Thomas Læssøehttps://svampe.databasen.org/observations/10589176

09-04-2026 10:12
Thomas Læssøehttps://svampe.databasen.org/observations/10587061

08-04-2026 20:33
Found 07-04-26, in Abies cephalonica. Diameter 1,

08-04-2026 10:39
FRANCIS FOUCHIERBonjour , je recherche en pdf cet article: KORF R

06-04-2026 21:36
 Viktorie Halasu
Viktorie Halasu
Hello, could anyone please send me the article wi

06-04-2026 19:40
Help with this one much appreciated, on rotting Fa
 I am reposting the finding of a Cosmospora species with new and more correct information.
I am reposting the finding of a Cosmospora species with new and more correct information.This was growing on the wood pf chopped trunks of an unknown tree, just below the outer skin of the bark (hence not fully exposed). According to experts in this forum, the perithecia are embedded on the substratum of another Deuteromycetes fungus carpeting the log. I managed to grow pure colonies of the anamorph which I can't really tell if they are Fusarium or Fusarium-like Acremonium, but they are white cottony colonies.
DATA on TELEOMORPH:
=================
Ascocarp
Ascocarp morphology: Clustered ostiolate perithecia
Acocarp colour: Bright red, then blackening when old; purple-blue in KOH, orange-yellow in lactic acid
Ascocarp diameter: 0.16 – 0.32 mm (mean: 0.23 mm)
Ascocarp texture: Rough, Granulated or minutely tuberculate, ostiole with very fine setae
Ascocarp shape: Spherical then pyriform, opening at the apex by a tiny narrow ostiole sometimes widening to a cupulate shape
Paraphyses not numerous, filamentous, very thin and hyaline, inconspicuous and do not take the stain very well.
Ascum
Ascospore release: through an apical orifice without an operculum
Asci: cylindrical to subclavate, slender, slightly bent ot curved, tapering gently towards the base.
No. of Spores 8
Tunic (Wall) Uni-tunicate, hyaline and do not stain well
Ascum length (range) 70 - 100 µm
Ascum length (mean) 84 µm
Ascum width (range) 6.8 - 7.5 µm
Ascum width (mean) 7.1 µm
Ascum L:W ratio 11.8
Iodine reaction (J +/J -) J-ve (but I'm not sure there is a blackish shadoe at the tip with IKI)
Orifice or ascum rim Rim slightly revolute, oriffice narrow, canal-like, surrounded by a thich asus wall.
Ascospores:
Spore length: (range) 11.46 - 16 µm
Spore length: (mean) 13.7 µm
Spore width: (range) 4.76 - 7.44 µm
Spore width: (mean) 6.3 µm
Spore Q factor (range): 1.84 - 2.85 µm
Spore Q factor (mean): 2.2
Spore shape: Fusiform to navicular with a constriction at the central septum
Spore septa 1
Spore surface: Smooth or finely rugose when observed at high resolution with LACB
Oil bodies: Two, one at each side of the septum, often seen as a small amorphous body of many aggregates coalescing together until finally forming a distinct globular oil body.
Remarks Spore quite variable in size.
Location: Malta, central mediterranean.
Your suggestions are welcome!

Nectriaceae (Hypocreales, Ascomycetes) as follows:
1: On scale insects and adelgids : NO --> couplet 4
4: Ascomma superficial. orange. red to dark red, KOH+: anamorph not Fusorium merismoides : YES --> couplet 5
5: Ascospores > 10um long: YES (13.7um) -->22
22: Ascospores < 15um long: YES (13.7um) -->23
23: Ascospores > 4um wide: YES (6.3um) --> 32
32: Ascospores < 6um wide: borderline if NO -->33 / if YES -->43
33: Herbicolous. fructicolous. corticolous. or lignicolous. not fungicolous : NO, it is likely a fungicolous colony (although I still have a small doubt!) --> 36
36: Ascospores smoth to spinulose, verruuculous or tuberculate, not striate; anamorph
Fusarium or unknown; tropical and temperate regions: YES --> 38
38a:Ascospores tuberculate. 9.5-11(-12) x 5.5- 1(- 7.5) um, anamorph Acremonium-like.
with salmon colonies: NO, Ascospores longer
38b: Ascospores smooth to spinulose or verruculose: anamorph Acremonium-like Fusarium
or unknown: YES --> 39
39a. Perithecia with hyphal hairs arising from the surface of lhe perithecial wall, ascospores
12-13 x 5-7 um; anamorph unknown --> C. rubrisetosa : I don't think there are hyphal hairs and ascospores longer, not so sure!!!
39. Perithecia glabrous: ascospores 9.5-15 X 4.5- 7 um; anamorph Acremonium-like or
Fusarium: Probably YES --> 40
40a: Ascosporcs (10-)11.5-14.5(-16) x (5-)5.5-7.5(-10) um. smooth to slighlly spinulose; anamorph Acremonium-like. On wood possibly fungicolous, central and northern Africa --> C. meliopsicola.
40b. Ascospores 9.5-15 x 4.5-7.0um spinulose; on immersed ascomyceles; anamorph
Fusarium from north temperate New Zealand --> 41
I'm excluding lead 40b because spores are not spinulose, distribution region does not match.
Any one famigliar with C. meliospicola ?

43a: Perithecia with a fringe of hyphal hairs around the apex; ascospores
(12- )13-16.5(- 17) x (5.5 - )6-7.5(- 8) um; anamorph Fusarium; On non-valsaceous
fungi C. pseudoflavoviridis: No hyphal hairs, not on fungi : NO
43b: Perithecia glabrous or with setae surrounding the ostiole: ascospore, 8-18.5 X 4-8 um: OK --> 44
44a: Petithecia with setae surrounding ostiole: Ascospore. 12-18 x 4-8 um: anamorph
Fusarium: grows on bark; New Zealand --> C. dinglae. Fungicolous and not new Zealand so NO
44b. Perithecia glabrous: anamorph Aremonium-like Fusarium, or unknown: on Xylariaceae or wood; temperate or tropical regions --> 45 YES
45a Europe or United Stales (New Jersey): YES --> 46
45b Tropical America. central and southcrn Africa NO
46a. On Valsa sorbi, Europe: ascospores (13- )13.5- 16.5{-18.5) x (5.5- )6-7(- 7.5) )um;
anamorph Fusarium --> C. stilbosporae
46b. On dead. scale-like leaves of Chamaecyparis possibly on immersed asoomycetes: United
Stales (New Jersey): ascospores 8-15 x 7-8 um, anamorph unknown --> C. thujana (NO)
CONCLUSION
C. meliospicola if width of spores is > 6um; African region
or
C. stilbosporae if width of spores is < 6um; European but on Valsa sorbi ?? (What is this??)















 IMG-9024s-0001.jpg
IMG-9024s-0001.jpg